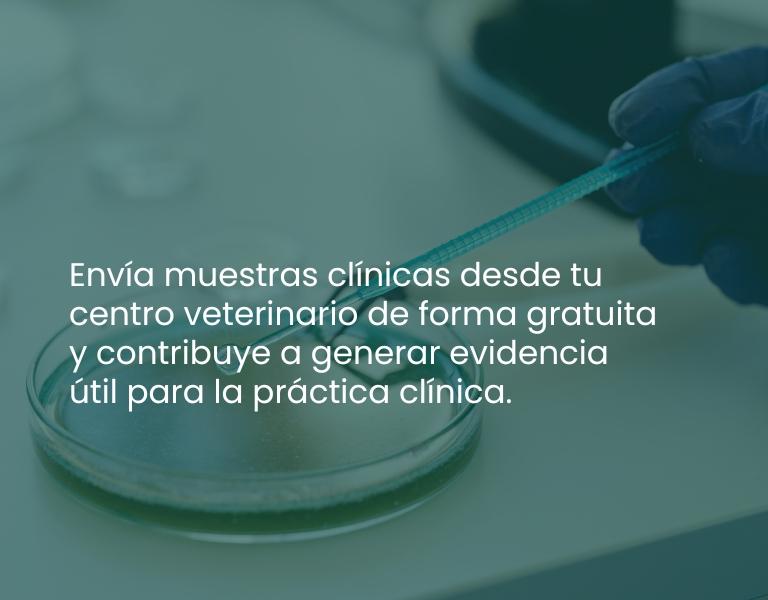

-

Reacreditación Certificados OCV
En septiembre se iniciará el período para subir a la aplicación del Consejo General, los documentos que acrediten la superación del baremo aprobado.
-
.jpg)
REVISTA NÚM 1 - "INFORMACIÓN VETERINARIA" 2026
-

Rostros de la Veterinaria
-

IV Congreso Internacional de Sanidad y Bienestar Animal
-
Participa en el estudio sobre resistencias a los antimicrobianos



.jpg)

.jpg)


.png)



.jpg)













.png)
.png)
(1).png)



